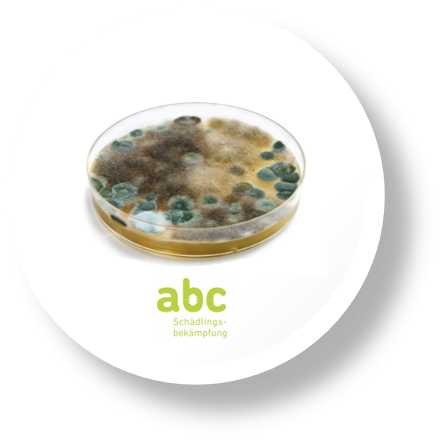
abc- Schädlingsbekämpfung Kammerjäger, Hauptplatz in Schwyz

Über abc- Schädlingsbekämpfung Kammerjäger Hauptplatz in Schwyz
"Beratung und Prävention" heisst das moderne Betätigungsfeld des Schädlingsbekämpfers
Beratung
Die Anforderungen an die Schädlingsbekämpfung haben sich seitens des Gesetzgebers - und damit auch seitens der Verbraucher - und der Industrie in den letzten Jahren gewandelt. In Verordnungen und Industriestandards finden sich Hinweise auf die Anforderungen an die Schädlingsbekämpfung.
Im Prinzip ist allen Schriften gemeinsam, dass ein Schädlingsbefall möglichst verhindert, zumindest früh erkannt und wenn nötig nur mit geringstem Mitteleinsatz bekämpft werden soll. Dies alles soll lückenfrei und nachvollziehbar dokumentiert werden. Überdies wünschen die Kunden der Industrie auf bevorstehende Audits, was die Pest Control betrifft, gut vorbereitet zu werden.
Die geforderten Punkte und damit die Zufriedenheit der Kunden erfüllen bzw. erreichen wir Schädlingsbekämpfer mittels der Integrierten Schädlingsbekämpfung (Integrated Pest Management, IPM), die sich im Wesentlichen in drei Abschnitte gliedert.
Prävention
Ziel ist es, Gebäude möglichst gegen das Eindringen von Schädlingen abzusichern, zumindest Nischen und Hohlräume abzudichten. Idealerweise erfolgt dies bereits während der Bauplanung in Zusammenarbeit mit den Architekten. Leider sieht die Realität anders aus, und so muss das Abdichten mühsam und mit viel Mehraufwand Schritt für Schritt während der Nutzung durchgeführt werden.
Nur eine erfahrene und geschulte Fachkraft mit fundiertem Wissen über die Biologie der Schädlinge sowie mit Kenntnissen über bauliche Möglichkeiten ist in der Lage, ein fundiertes Konzept für ein schädlingsfreies Gebäude zu erstellen.
Allgemeingültige Ansatzpunkte hierfür sind:
- Bepflanzungen in unmittelbarer Gebäudenähe. Sie bieten Nistplätze für Nager.
- Leuchtreklame am Gebäude lockt Insekten und danach Spinnen an.
- Schlecht schließende Türen sind Eintrittspforten für allerlei Getier.
- Kanalisation und Hohlböden und -decken sind Lebensräume für Schädlinge.
- Rolladenkästen bieten Platz für Wespennester und überwinternde Insekten.
- Freistehende Abfallbehälter locken Schädlinge an.
- Gebäudeisolationen bieten Ameisen und Mäusen Unterschlupf.
- Dachränder sind Land- und Ruheplätze für Vögel.
- Geöffnete Fenster und Tore sind eine Einladung für Fluginsekten.
Zudem ist die passive Einschleppung durch eine strenge Wareneingangs- und Lagerkontrolle zu verhindern.
Monitoring
Eine systematische Überwachung von Insekten mittels Klebe- und UV-Fallen und von Schadnagern mittels Köder-boxen und Köder oder Lebendfangfallen ermöglicht das frühzeitige Erkennen eines Befalls. Außerdem wird gleichzeitig die Lage des Befallsherdes, das Maß der Ausbreitung sowie die Entwicklungsstadien der Schädlinge erfasst.
Behandlung Die erforderliche Bekämpfungsmaßnahme kann nach dem Erkennen eines Befalls rasch und gezielt, das heißt mit minimalem und kontrollierten Einsatz von chemischen Mitteln durchgeführt werden
Schädlingsbekämpfung zBsp. von Bettwanzen, Deutschen und Amerikanischen Schaben, Kakerlaken, Spinnen, Vogelabwehr, Marderabwehr, Entfernen von Wespennestern. Reinigungen: Tatort- und Messie-Reinigung, Schimmelpilz-Beseitigung, Behandlungen im Auto, kontrollierte Lüftungs- und Wohnungs-Desinfektion sowie Entkeimung, Rauchgeruch, Nikotin, Brandgeruch, Biergeruch, Erbrochenes, Urin, Milchsäure, Buttersäure, Schwefel, Diesel, Leichengeruch, Verwesungsgeruch, Keim, Viren und Bakterien, Geruchsentfernung, Geruchsneutralisation, Gestank, Brandschaden, Wasserschaden, Sanierung.
Unser Einsatzgebiet erstreckt sich in folgenden Kantonen der Schweiz: Aargau, Appenzell, Ausserrhoden, Appenzell, Innerrhoden, Basel-Landschaft, Basel-Stadt, Bern, Freiburg, Genf, Glarus, Graubünden, Jura, Luzern, Neuenburg, Nidwalden, Obwalden, Schaffhausen, Schwyz, Solothurn, St. Gallen, Tessin, Thurgau, Uri, Waadt, Wallis, Zürich, Zug.
Wenn der Mieter zum Messie wird – wir reinigen schnell und gründlich
In den letzten Jahren haben wir uns auf die Reinigung von Messie-Wohnungen spezialisiert und bieten einen gründlichen Rundum-Service an.
Die herkömmliche Reinigung reicht in diesem Fall nic

Garten- & Landschaftsbau
Garten- & Landschaftsbau